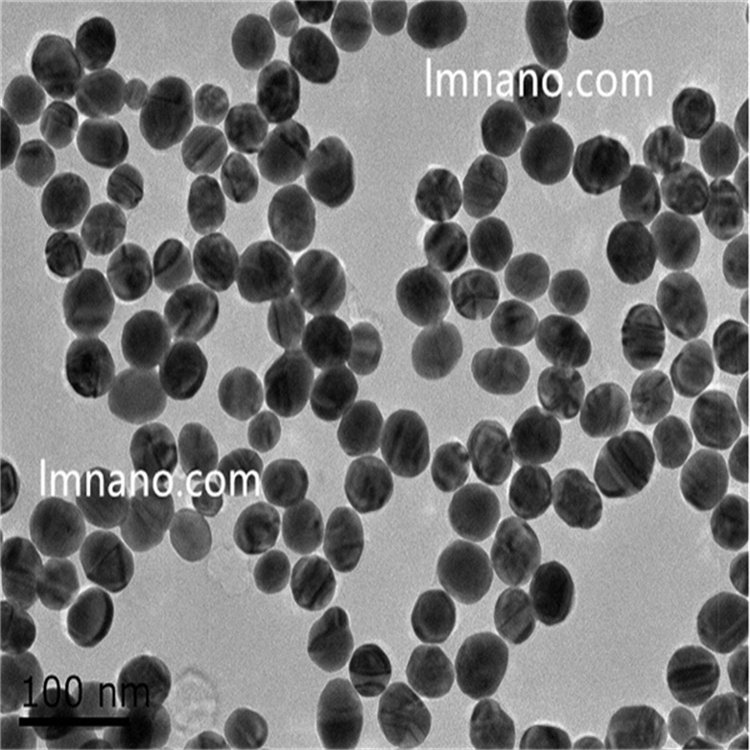

<li id="cgmmu"></li>
<rt id="cgmmu"></rt>
 ╣®æ¬ĮŃy╝{├ū╦¾ūė
╣®æ¬ĮŃy╝{├ū╦¾ūė
 ųą┐Ų└ū°QPEG╗»
ųą┐Ų└ū°QPEG╗»
 ųą┐Ų└ū°QĮ╝{├ū╦▄
ųą┐Ų└ū°QĮ╝{├ū╦▄
.jpg) ╣®æ¬č§╗»õX╝{├ūŠĆ
╣®æ¬č§╗»õX╝{├ūŠĆ
.jpg) ╣®æ¬ŠG╔½Š█▒Įęꎮ
╣®æ¬ŠG╔½Š█▒Įęꎮ
.jpg) ╣®æ¬╦«ąįŪ“ą╬Ńy╝{
╣®æ¬╦«ąįŪ“ą╬Ńy╝{
.jpg) ╣®æ¬å╬Ęų╔óŠ█▒Įęę
╣®æ¬å╬Ęų╔óŠ█▒Įęę
.jpg) ╣®æ¬¶╚╗∙╗»╦─č§╗»
╣®æ¬¶╚╗∙╗»╦─č§╗»
 ╣®æ¬µ£├╣ėH║═╦žą▐
╣®æ¬µ£├╣ėH║═╦žą▐
 ╣®æ¬ČÓ┴ŻÅĮČ■č§╗»
╣®æ¬ČÓ┴ŻÅĮČ■č§╗»
.jpg) ╣®æ¬ČÓŠ█┘ć░▒╦ßą▐
╣®æ¬ČÓŠ█┘ć░▒╦ßą▐
╣®æ¬╦«ąįŪ“ą╬Į╝{
╣®æ¬╦«ąįŪ“ą╬Į╝{
.jpg) ╣®æ¬610nm╦«
╣®æ¬610nm╦«
.jpg) ųą┐Ų└ū°QŠ█▒Įęꎮ
ųą┐Ų└ū°QŠ█▒Įęꎮ
 ╣®æ¬Ųš¶ö╩┐╦{╝{├ū
╣®æ¬Ųš¶ö╩┐╦{╝{├ū
 ╣®æ¬╝{├ūµćĘ█50
╣®æ¬╝{├ūµćĘ█50
 ╣®æ¬Ń~╝{├ūŠĆę╗ŠS
╣®æ¬Ń~╝{├ūŠĆę╗ŠS
 ╣®æ¬80nm╝{├ū
╣®æ¬80nm╝{├ū
 ╣®æ¬50nm╝{├ū
╣®æ¬50nm╝{├ū
 ╣®æ¬╝{├ūŃfĘ█50
╣®æ¬╝{├ūŃfĘ█50
<rt id="wgswm"></rt>
<rt id="wgswm"></rt>